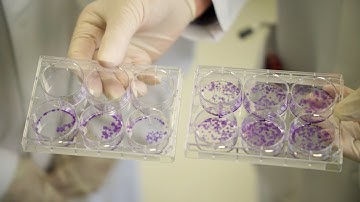
Fighting cancer with precision oncology

⬇ DOWNLOAD NOW
Kalau muncul iklan pop-up, tutup lalu klik tombol kembali
Download lagu OncoKDM: enhanced precision for your laboratory secara gratis hanya untuk keperluan promosi. Dukung artis favorit kamu dengan membeli musik original di iTunes atau platform resmi lainnya.
 OncoKDM Clinical Decision Software
OncoKDM Clinical Decision Software
 OncoKDM - Supporting oncologists and laboratory heads
OncoKDM - Supporting oncologists and laboratory heads
 Best of OncoKDM Launch "From Big Data To Useful Knowledge"
Best of OncoKDM Launch "From Big Data To Useful Knowledge"
 Webinar: How to turn genomic data into precision medicine?
Webinar: How to turn genomic data into precision medicine?
 OncoKDM Launch (2017) - Dr Laes, OncoDNA Chief Scientific Officer
OncoKDM Launch (2017) - Dr Laes, OncoDNA Chief Scientific Officer
 VHIO: Translation Toward precision oncology
VHIO: Translation Toward precision oncology
 OncoKDM Interpretation platform
OncoKDM Interpretation platform
Fighting cancer with precision oncology
Fighting cancer with precision oncology